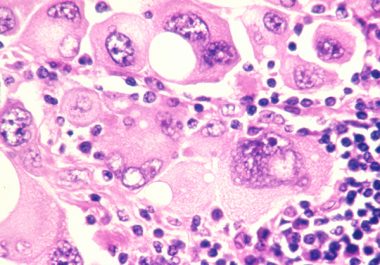
New Immunotherapeutic Tested in Clinical Trial

Identifying Patients at Risk for Life-threatening Adverse Effect of Chemotherapy
A genetic biomarker may help identify breast cancer patients at increased risk for heart damage caused by anthracycline chemotherapy.


A genetic biomarker may help identify breast cancer patients at increased risk for heart damage caused by anthracycline chemotherapy.

Researchers are using genetic tests to help identify breast cancer patients at risk for potentially life-threatening complications of chemotherapy. Blood clots that develop in the veins of patients – known as venous thromboembolism or...

A recent study reports that how pediatricians talk to parents can affect whether or not they chose to have their child vaccinated against human papillomavirus (HPV). For pediatricians and parents of adolescents, across the...

Each of the three obesity-related factors, body mass index (BMI), waist size, and type 2 diabetes, was associated with liver cancer risk in a large study.
An investigational immunotherapeutic was safe, tolerable, and showed some activity against melanoma in a phase I clinical trial.

The number of Hispanic breast cancer patients in California getting care and participating in a clinical trial increased, a study found.

The lack of androgen receptor protein may contribute to racial disparities in survival for women with this aggressive form of breast cancer.

In an early-phase trial, investigators study whether combining immunotherapies expands “tumor-specific immune activation.” A small phase Ib study of a combination of an investigational cytokine-based immunotherapy and the checkpoint inhibitor pembrolizumab (Keytruda) showed promise...

Researchers seek to understand why some patients do not respond to immunotherapeutics while others achieve durable outcomes.

Black patients in highly segregated neighborhoods were less likely to have lung cancer surgery.